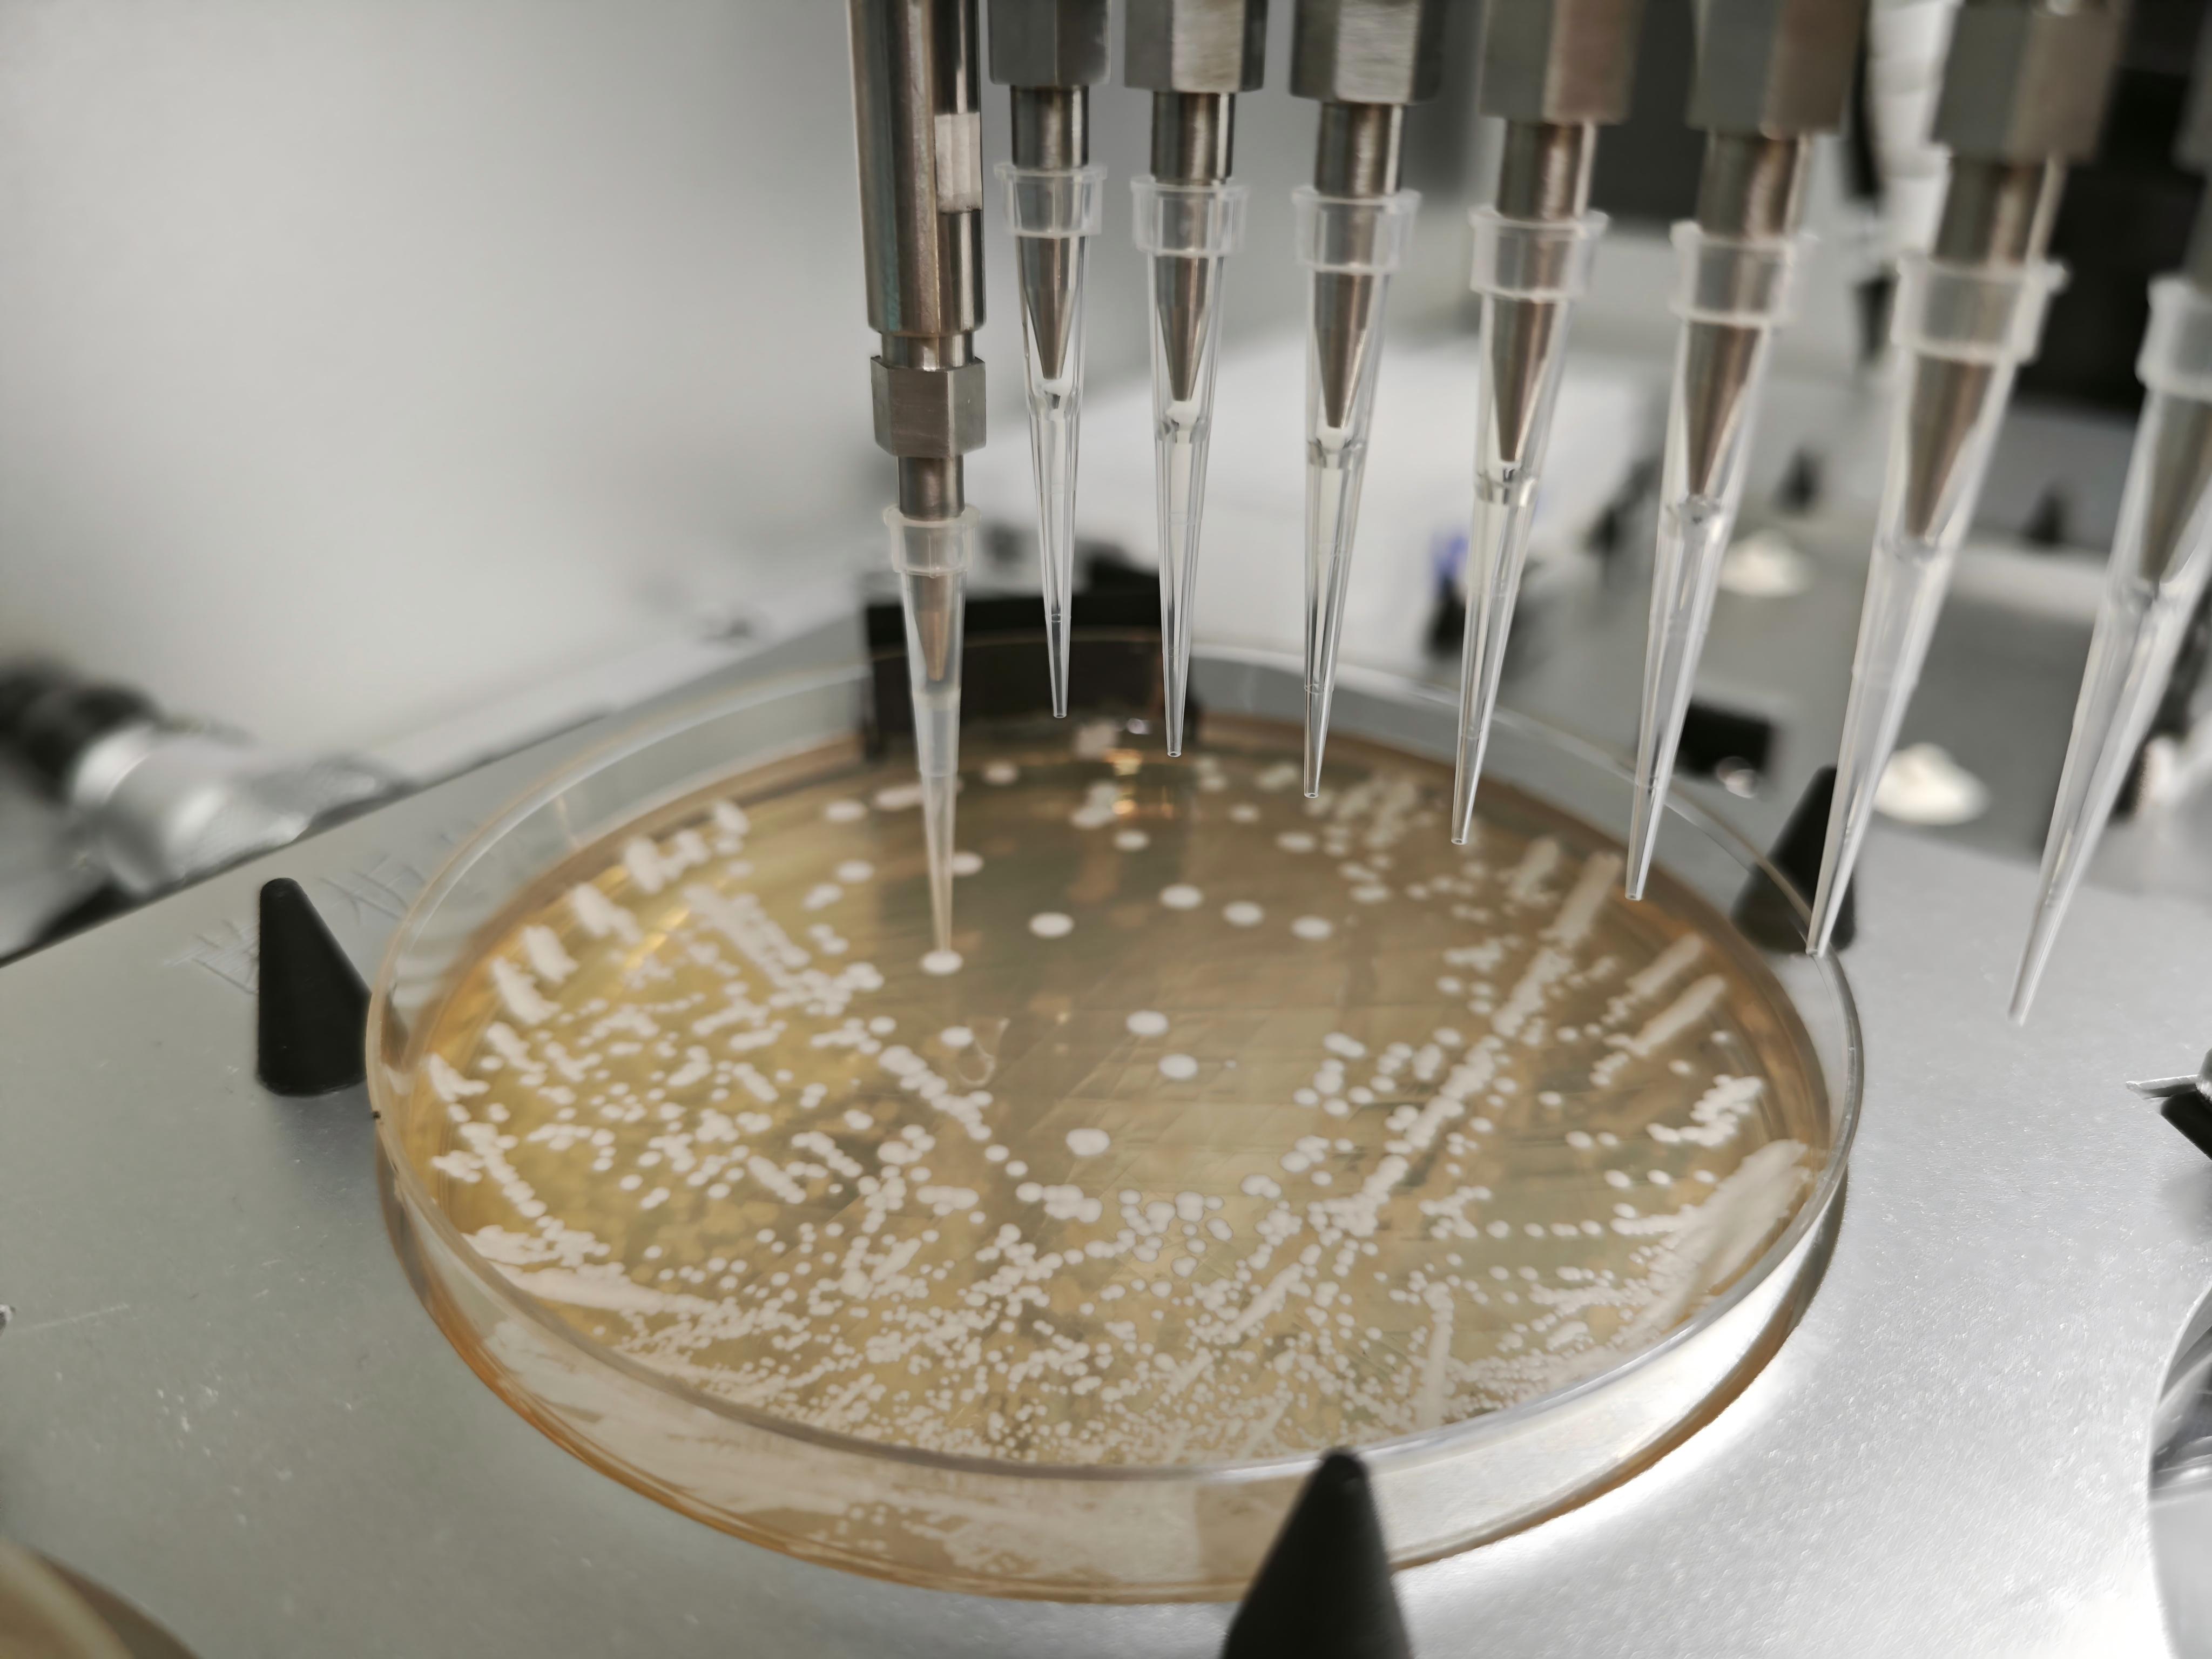

INNOVATION
Built for Speed, Scale, Impact, and Partnership
Intelligent Platform Technology
CataEngine™:
Our Modular Synthetic Biology Platform for Accelarated, High-Impact Innovation
· Supports a broad range of microbial hosts and product classes
· High-throughput automation and AI-driven optimization enable faster development cycles at reduced cost
· Track record of excellence and high milestone success rates
Automation and Digitization
We leverage automation, digitization, and AI optimization to accelerate R&D and manufacturing
· Automated workflows ensure consistent, reliable outcomes
· Digital tracking enables full traceability with real-time visibility and insights
· AI-driven optimization enhances efficiency while maintaining the highest quality standards

Data-Driven QC & Quality by Design

Integrated Bioprocess Development

Formulation and Application Capability

Our bench-to-scale technology platform turns ideas into market-ready solutions faster and more cost-effectively. Through collaborative commercial models and a proven track record in strain and process optimization, scale-up, and manufacturing execution, we deliver results that transform innovation into real-world value for our partners.